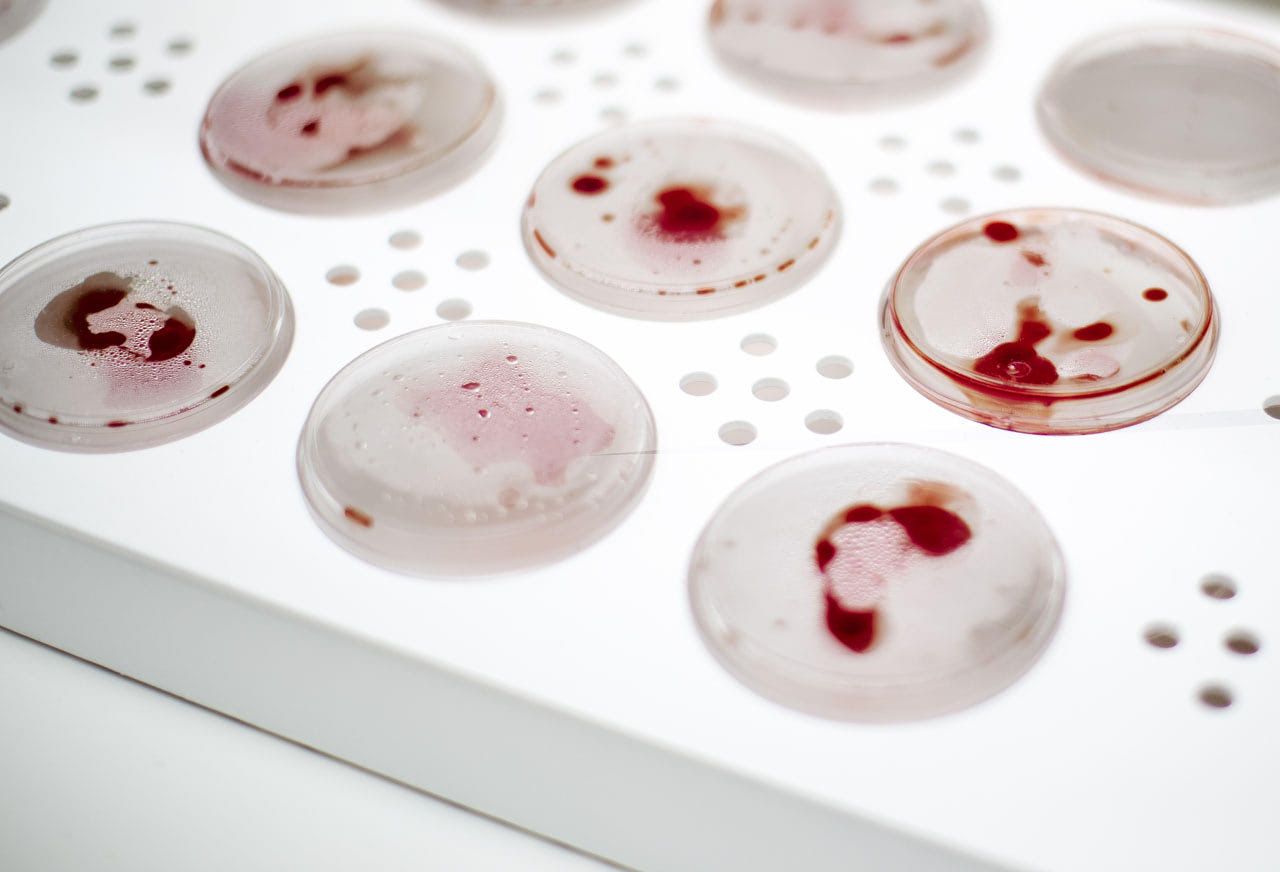

Our In Vitro Meat Cookbook has inspired many people around the world. Just recently, we had the BBC over at our headquarters to see what makes us thick.
This idea of in vitro meat certainly is — at least for now — an elaborate portion of food for thought (meat oyster anyone?). And with this in mind, the alumni of Tecnológico de Monterrey university, Mexico City, challenged themselves to speculate on possible (local) futures for in vitro meat and boil up thoughts on how Mexican cuisine may change along the way.
But first
Mexico city is a metropolis with approximately 8.8 million inhabitants. It faces the 'common' problems for any big city: traffic, pollution, overpopulation and delinquency. Yet it stands out for it also faces some 'less common' problems. Think earthquakes, sinking buildings and water shortages.
Each of these issues are rooted in a long history of a series of (bad) decisions that all seemed to lack any future perspective. At that time, building a city over a lake perhaps seemed like a good idea, but today the chilangos (residents of Mexico City, ed.) have to deal with the consequences of such a decision.
Nevertheless, the citizens of Mexico City do enjoy a vibrant culture and all the wicked food flavors this entails. Having that said, foodies in Mexico City will have no problem at all finding the corn, cheese and chilli combos to satisfy their every craving, from the southern Oaxaca to the northernmost Tijuana — let alone the local surprises available at the many street food stands.
These two aspects of the metropolis where addressed during the workshop by the young talents, led by industrial designer Mariana Pedroza from Antefuturo. Working with the Pyramid of Technology toolkit, this creative session resulted in three future-proof scenarios that each show how speculative design holds the ability to deliver fresh insights that may inspire many more to come. Let's dig in.
Scenario 1: Filter
It's 2040 and Mexico City is suffering through an extreme water crisis. Therefore team Filter has envisioned traditional aguas frescas (fruits water) — but with a twist.
At their street stand, they are turning urine into water. Here's how it works: First you go to the special urinals where your urine is analyzed and stored. Based on this analysis, they recommend the adequate drink in order to keep you healthy.
At the bar there are different beverages available, all made from the recycled water of the city sewage, to which you just have contributed.


Scenario 2: Autonomous Street Vendor
It's 2050 and mobility in the city has drastically changed: Cars are no longer taking up all the space, as bicycles have popped up as the standard mode of transport.
As a result, the days of loud food trucks, ice cream vendors or pan dulce sellers are over. Instead, we now have Autonomous Street Vendor Drones: Floating humming drones that substitute the megaphones of food trucks. You'll hear them buzz around town, and you simply take a cycling break to enjoy a hot tamal oaxaqueño. Cheers!

Scenario 3: Meat Biohacking Lab
As emerging technologies drive new business and service models, governments must rapidly create, modify, and enforce regulations — not always in favor of its citizens.
In this scenario, in vitro meat is forbidden in Mexico City due to ill-advised security concerns. However, as the food shortage in many neighbourhoods grows, this has led to the creation of so-called Meat Biohacking Labs: underground facilities where citizens meet to produce (human) in vitro meat for self- consumption.

Pictures and project by Mariana Pedroza
PS: Do you want to organize your own next nature workshop? You can! Drop us a line at academy[at]nextnature[dot]com.


Comments (0)
Share your thoughts and join the technology debate!
No comments yet
Be the first to share your thoughts!